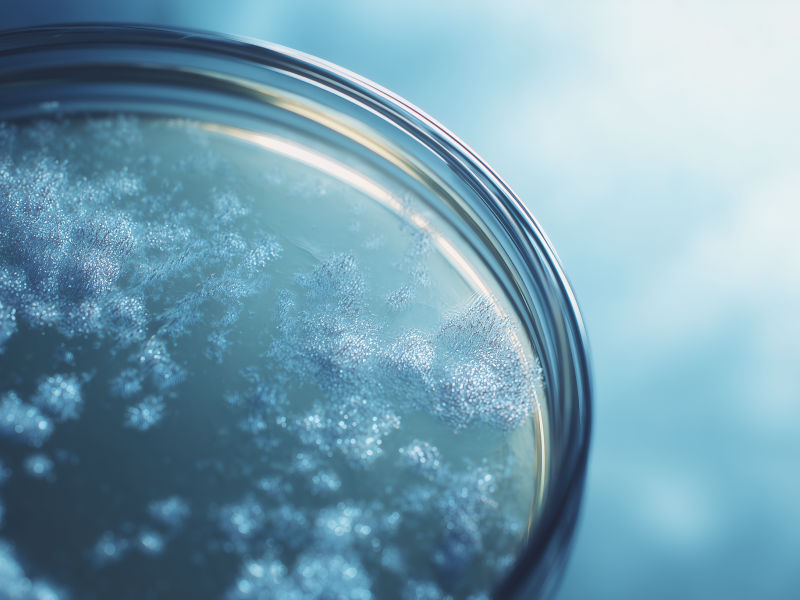
260120_CERTANIA_GroupeIcare_AI_PetriDishBacteria

Life Sciences
Our service segment Life Sciences focuses on researching pharmaceuticals, medical devices, and healthcare diagnostics. The CERTANIA network upholds rigorous scientific standards and meets international requirements.
ClinicalResearch
Clinical research from early development to approval: clinical studies phase I-IV, data management, biometrics, pharmacokinetics and regulatory compliant IT and data solutions for reliable study results.
Learn more
As a renowned Research Consulting Organisation (RCO) and state-of-the-art laboratory, accredited according to DIN ISO 9001:2015 and DIN EN ISO/IEC 17025:2018, we enjoy an excellent reputation in the development and testing of nutraceuticals, cosmetics and medical products. Whether analytics, cell cultures or clinical studies: our broad range of services guarantees the highest standards of quality and expertise worldwide.

We have been dedicated to clinical research into women's health for over three decades. At our Berlin study center, we organize complex, cycle-dependent procedures such as daily transvaginal ultrasound examinations and regular blood samples in a reliable and structured manner – with a particular focus on proof-of-concept and dose-finding studies in areas such as contraception, endometriosis, fertility therapy, hormone replacement therapy and sexual medicine. Our experienced gynecological team, medically trained staff and an efficient recruitment system ensure high data quality in all clinical phases.

We have been developing specialised software and services for drug safety since 1993. Our GxP-compliant PV database saphëus® is provided as SaaS and enables safe, efficient and compliant case management – from ICSR processing and medical documentation to reports such as PSUR and DSUR. We also provide literature monitoring, regulatory submissions and modular support services for small and medium-sized pharmaceutical companies. We combine technological development, data security and in-depth regulatory expertise to create an integrated solution for pharmacovigilance.

From acquisition to validation and analysis, we are fully dedicated to your study data: Our flexible EDC systems, eCRF and eDiary/ePRO solutions adapt quickly and efficiently to any research design. Data integrity and CFR 21 Part 11 compliance are firmly anchored in our IT practice. Our biostatistics, pharmacokinetics and pharmacodynamics teams support projects through all development phases – right up to marketing authorisation. We have been working according to CDISC and GAMP 5 standards since 2007 and develop customised, high-quality data solutions through our own programming group.

As a specialised service provider for clinical development, we offer planning, implementation and evaluation of studies – from early Phase I studies through to approval. We combine scientific depth with efficient project management and the highest GxP standards. Our portfolio includes study design, study plans, monitoring, project management and medical-scientific consulting. Together with our sister companies, we also support biometrics, data management and PV – seamlessly integrated and flexibly scalable. With our own infrastructure and experienced teams, we reliably realise challenging projects.
HealthcareServices
Pharmaceutical analysis, hygiene and quality management as well as laboratory diagnostics: stability tests, GMP-compliant tests, audits and quality control materials for safe, effective and reliable healthcare products.
Learn more
The shelf life of drugs under environmental conditions is our speciality: With sophisticated stability tests, we ensure that drugs remain safe and effective throughout their life cycle. As an FDA-approved laboratory, Alphalytik enjoys an excellent reputation in the field of pharmaceutical analysis and has long-standing customer relationships in the pharmaceutical industry.

With over 25 years of experience, our laboratory is a pioneer in air pollution control, specialising in microbiological hygiene in occupational health and safety. Our services range from air pollution control tests for HVAC systems to drinking water analyses and hygiene training. We also optimise production processes and validate cleaning equipment in hospitals. And our experts are involved in industry committees and research projects to ensure the highest standards of hygiene everywhere and at all times.

As a renowned Research Consulting Organisation (RCO) and state-of-the-art laboratory, accredited according to DIN ISO 9001:2015 and DIN EN ISO/IEC 17025:2018, we enjoy an excellent reputation in the development and testing of nutraceuticals, cosmetics and medical products. Whether analytics, cell cultures or clinical studies: our broad range of services guarantees the highest standards of quality and expertise worldwide.

For more than 30 years, we have been developing specialized quality control samples and reference materials, especially for virus diagnostics. Through close cooperation with laboratories and our scientific network, we recognize trends early on and react precisely to new requirements. Our solutions support both internal and external quality assurance and strengthen diagnostic accuracy worldwide. We combine experience, research and continuous development – for reliable, safe and modern laboratory medicine.
MedTech
Testing, engineering and consulting services for medical and pharmaceutical products: Laboratory, biocompatibility and implant testing, validation and regulatory support for safe, international approvals.
Learn more
Since 1995, our multidisciplinary teams have been working to ensure the quality and conformity of medical and pharmaceutical products with practical solutions. We combine microbiological and physico-chemical testing, biocompatibility and toxicology testing, process validation, qualification of devices and cleanrooms as well as sound regulatory advice. With over 500 customers – from start-ups to international manufacturers – we are active worldwide and fulfil the strictest quality standards.

Accredited mechanical testing and technical services for implants and medical devices are the focus of our services: Since 2007, we have been supporting the approval process with tests according to ASTM, ISO and DIN standards as well as customised test setups. We carry out load, durability and functional tests and prepare biomechanical documentation for regulatory procedures. With state-of-the-art equipment and international accreditation, we guarantee safe, reliable and standard-compliant product evaluations.
Food & Consumer Goods
We safeguard the safety and quality of food and consumer goods with independent testing, inspection, and certification services. Our experts deliver thorough microbiological and chemical analyses, and inspections aligned with Good Agricultural Practice (GAP) guidelines.
Food&Environment
Analysis, research and consulting for food, environment and agriculture: chemical and microbiological testing, hygiene and quality management, regulatory approvals and scientific validation for safe products and sustainable markets.
Learn more
With over 25 years of experience, our laboratory is considered a pioneer in air pollution control, specializing in microbiological hygiene in occupational health and safety. Our services range from air pollution control tests for HVAC systems to drinking water analyses and hygiene training. We also optimize production processes and validate cleaning equipment in hospitals. And our experts are involved in industry committees and research projects to ensure the highest standards of hygiene everywhere and at all times.

As a renowned Research Consulting Organisation (RCO) and state-of-the-art laboratory, accredited according to DIN ISO 9001:2015 and DIN EN ISO/IEC 17025:2018, we enjoy an excellent reputation in the development and testing of nutraceuticals, cosmetics and medical products. Whether analytics, cell cultures or clinical studies: our broad range of services guarantees the highest standards of quality and expertise worldwide.

With over 30 years of experience, we are the experts for reliable laboratory analyses in food, water and hygiene testing – based on profound know-how from previous activities in environmental analysis, communal catering, catering and medical examinations. Today, the range of services includes state-of-the-art hygiene tests, microbiological and chemical tests as well as analytical services for medical issues. Quality assurance is carried out according to international standards, supplemented by many years of routine and high technical precision.

We combine over 25 years of experience in hygiene, safety and quality management: Having emerged from the former LSG Hygiene Institute and later becoming part of TÜV SÜD, FSI has been anchored in the CERTANIA Group under a new name since 2021. Our organization develops and tests according to established and proprietary standards and supports companies in minimizing health risks, ensuring food safety and permanently improving product quality. Audits, laboratory analysis, consulting and digital tools interlock seamlessly and create efficient, sustainable quality management.

Sound environmental analysis and qualified hygiene consulting are our speciality: In our laboratories, we analyse water, soil, air, food and other materials according to the latest scientific standards. Our team of experienced experts analyses environmental and health-related contamination precisely and reliably. We also advise public and private organisations on hygiene management – from risk analysis to the implementation of effective measures. We have been DAkkS-accredited for an unlimited period since 2020 and carry out tests in accordance with DIN EN ISO/IEC 17025:2018.

Since 2003, we have been supporting companies in the safe and compliant authorization of plant protection products, biocides, fertilisers and biostimulants in Europe. We prepare complete dossiers for EU and national procedures, carry out risk and data gap analyses and advise on maximum residue limits, efficacy and environmental models. In addition, we support market entry strategies, coordinate joint registrations and structure cost sharing for active substance authorizations. With sound regulatory and scientific experience, we pave the way for you through the jungle of requirements and ensure safe products in a demanding market.

As an accredited testing laboratory, we combine precise analysis with technical expertise and comprehensive advice. We analyse food, drinking water, environmental samples and numerous other matrices according to the highest standards – and deliver reliable results for well-founded decisions. In addition to independent expert reports, we develop customised HACCP concepts and support you with quality and environmental management systems. Our accreditation in accordance with DIN EN ISO 17025:2018 also includes sampling and legionella testing – from inventory to communication with the authorities.

We provide reliable analysis based on our QM trilogy of GMP, GLP and DIN EN ISO/IEC 17025. Our laboratory supports projects in every phase - from heavy metal testing and residue analysis to cleaning and migration analyses, ecotoxicological studies and stability-related investigations. Another focus is on the sampling and analysis of environmental samples, especially water, including selected microbiological tests. As an approved drinking water testing centre and recognised training company, we combine technical excellence with practical support.

We have been combining state-of-the-art analysis with scientific advice for more than 40 years. We test food, animal feed, pharmaceutical and chemical products – from nutrient and contaminant analyses to biopharmaceutical tests and rapid emergency analyses. Our in-depth regulatory understanding and our precise laboratory work produce solutions that always fulfil the increasing requirements for quality and safety. This way, Triskelion supports companies and authorities alike in reliably assessing products and recognising risks at an early stage.
SupplyChain
End-to-end solutions for supply chain security and compliance: Audits, receiving and process controls, cargo compliance and technology-enabled services to increase efficiency, transparency and ESG goals in retail.
Learn more
As independent experts, we combine good faith receiving, picker accuracy, direct-to-store processes and cargo compliance into an end-to-end solution to secure supply chains in retail and industry. Our proprietary technology increases efficiency, optimises supplier structures and supports ESG goals. With more than 450 auditors in over 90 distribution centres, we offer reliable, scalable services that are the industry standard in the UK. As we expand into Europe, we are entering new markets such as Germany and France, strengthening the performance of modern supply chains.
Sports
Testing, certification and consulting services for sports surfaces, sports infrastructure and equipment: globally recognised expertise for quality, safety, innovation and sustainable standards in all sports and surfaces.
Learn more
Since 1993, Labosport has been one of the world's leading experts in sports surfaces, game technology and sports equipment. We test and certify artificial turf, running tracks, indoor systems and natural turf – internationally, independently and with precision. From planning to maintenance, we support operators, planners and manufacturers with scientific analysis, technical expertise and recognized standards.
Industrials
From material testing to renewable energy certification, we provide comprehensive testing, inspection, and certification services. Our expertise enables companies in the automotive, industrial, and energy sectors to consistently achieve the highest standards of performance and quality.
IndustrialAnalytics
Material testing, calibration and filtration technology: precise analyses, damage diagnostics, NDT services, aerosol and filter tests as well as comprehensive quality and safety tests for industrial applications.
Learn more
As a leading calibration laboratory that adheres to the highest standards, we offer one of the most comprehensive accredited ranges of services in the field of non-destructive testing. From ultrasonic, radiometric and photometric calibrations to magnetometry and hardness measurements, we ensure that measuring devices are precise and compliant across all industries. We also take on the maintenance, inspection and repair of testing and measuring systems and provide support with technical equipment sales and specialized training programs. Our work meets the highest quality standards and strengthens our customers' industrial performance in the long term.

We are an internationally recognized testing institute for aerosol filtration with a wide range of tests – from pipette tip filters, cabin air and gas turbine filters to complete devices such as room air cleaners and vacuum cleaners. Particle separation performance and adsorption capacities, such as activated carbon filters, are tested for industries ranging from the automotive industry to cleanroom technology. Good to know: Fiatec has exclusive distribution rights for ISO 12103-1 test dusts and comparable products.

Since 1995, we have been the experts for sound material analysis and tested quality – with metallography, optical emission spectrometry, fracture assessments and comprehensive damage analyses all under one roof. This makes us one of the world's first accredited calibration laboratories for optical emission spectrometers. Precise spark spectrometry in particular enables exact elemental analyses for industries such as automotive, aviation, transport technology and medical technology. In this way, we create reliable results for industrial decision-making processes using state-of-the-art testing methods and a clear quality standard.
IndustrialInspection
Non-destructive testing, material inspection and technical diagnostics: ultrasonic, radiographic, magnetic and hardness testing, acoustic and vibration analyses as well as fluidic expertise for maximum safety, quality and system reliability.
Learn more
For more than 45 years, the specialists at C.M.C. Sud have been among the international pioneers in non-destructive testing and safety-critical material inspections – from ultrasound and radiography technology to magnetic particle testing and heat treatment. With in-depth expertise in high-risk areas such as nuclear technology, energy and industrial manufacturing, we reliably ensure the integrity of safety-relevant components. We are also regularly involved in major international projects with state-of-the-art testing systems and in-depth expertise – and are regarded as a leading authority for precise, standard-compliant testing and inspection solutions.

When developing solutions for technical acoustics, sound insulation, system vibrations and flow technology, we benefit from half a century of experience. We support projects from the planning stage through to commissioning and optimization during operation. With our expertise, we support planners, manufacturers and operators in identifying the causes of noise and vibration problems and developing effective mitigation measures. Whether machine dynamics, immission control or pulsation studies: We combine analytical depth with practical recommendations to ensure reliable, safe and efficient systems.
RegulatoryAffairs
Consultancy, certification and compliance for chemicals, energy and industrial plants: regulatory strategies, REACH/CLP services, EZA certifications and global market access and compliance management for safe, compliant products and plants.
Learn more
Since 2007, we have been expertly guiding companies through the complexities of chemical regulations. Leveraging extensive experience, our teams develop sustainable registration strategies, prepare comprehensive dossiers, conduct exposure assessments, and create accurate safety data sheets. Through our international network, we also provide support in global markets, including the USA, Canada, and Korea. Certified to ISO 9001:2015, CS Regulatory is synonymous with structured processes, transparent quality, and dependable execution – ensuring that chemical products enter markets worldwide safely and in full regulatory compliance.

Since 2011, we have been using our expertise to help companies fulfil complex requirements for chemicals and hazardous substances. We advise on regulatory requirements, monitor legal changes and keep product portfolios up to date at all times. Our range of services includes the preparation of certifications, assistance with the transport of dangerous goods and recommendations for the sustainable and safe use of chemicals. As a reliable service provider for cosmetics, biocides, cleaning and surface treatment products, we ensure that products reach the market in compliance with regulations – efficiently, precisely and future-proof.

We successfully organise your access to demanding Asian markets: Our focus is on certification, conformity, product testing and inspections – from CCC and BIS to KC and other regulatory requirements. With offices in Frankfurt, the USA and China, we combine international reach with local expertise. Close links to authorities and testing laboratories enable fast, efficient and cost-transparent processes. Whether automotive, electronics, mechanical engineering or energy: we navigate through complex requirements and create smooth approval processes for your products.

Efficient, precise and compliant: this is how we certify renewable energy generation systems. Since 2020, we have been helping operators, developers and planners to connect wind power, photovoltaic, biogas and hydropower plants to the grid safely and in compliance with standards. Our focus is on type A, B and C system certificates and EZA declarations of conformity. With DAkkS accreditation in accordance with DIN EN ISO/IEC 17065 and a constantly growing wealth of experience, we are actively helping to drive forward the expansion of renewable energies in Germany and achieve the 2030 climate targets.
Buildings & Infrastructure
We provide comprehensive inspection, testing, and analytics for buildings, infrastructure and environments – ensuring safety, quality and compliance in materials, air, soil, and sports facility.
Buildings&Infrastructure
Comprehensive testing, hygiene, safety and compliance services for buildings and infrastructure. Laboratory analyses, risk management, fire and water safety, testing of technical and sports infrastructures as well as consulting and training for safe and sustainable environments.
Learn moreAs a leading engineering consultancy – with offices in the UK, Ireland and Cyprus – we combine technical excellence with digital innovation. We guide clients through the entire building lifecycle, from strategy to implementation, and offer the most comprehensive advice in the Buildings & Infrastructure segment, in terms of building regulations, fire safety and facade security.

As a leading consultancy for fire protection, building regulations and building safety, we have been supporting challenging construction projects in the UK since 2013. With in-depth technical expertise and a holistic approach, we develop fire safety concepts, advise on building regulation issues and provide support during planning and construction. Our expertise in legal safety requirements, risk assessment and technical inspections enables us to identify risks at an early stage and implement reliable solutions that comply with regulations. In short: we stand for the highest quality in safety, compliance and project management.

FES Group supports developers and contractors with compliance, testing, and sustainability consultancy services to deliver safe, efficient, and regulation-ready buildings across the UK.

ICA Group is a group of specialist companies delivering compliance, quality and safety services across the UK construction sector. Member companies provide building control approval, fire safety and building regulation consultancy, clerk of works and NEC supervisor services, and gas and electrical safety auditing. Working across residential, commercial, education, industrial and mixed-use developments, ICA Group's specialists support projects from initial design through to completion – ensuring regulatory standards are met and the safety of people in and around buildings is protected.

Sound environmental analysis and qualified hygiene consulting are our speciality: In our laboratories, we analyse water, soil, air, food and other materials according to the latest scientific standards. Our team of experienced experts analyses environmental and health-related contamination precisely and reliably. We also advise public and private organisations on hygiene management – from risk analysis to the implementation of effective measures. We have been DAkkS-accredited for an unlimited period since 2020 and carry out tests in accordance with DIN EN ISO/IEC 17025:2018.

Labortest is an independent Italian provider of accredited laboratory testing and structural inspection services. From construction materials and soil analysis to structural diagnostics and on-site investigations, Labortest supports organisations in managing technical risk and delivering auditable, regulatory-certain quality across the full asset lifecycle.

As an accredited testing laboratory, we combine precise analysis with technical expertise and comprehensive advice. We analyse food, drinking water, environmental samples and numerous other matrices according to the highest standards – and deliver reliable results for well-founded decisions. In addition to independent expert reports, we develop customised HACCP concepts and support you with quality and environmental management systems. Our accreditation in accordance with DIN EN ISO 17025:2018 also includes sampling and legionella testing – from inventory to communication with the authorities.

ÖHMI Service offers a comprehensive range of services relating to quality assurance, process management, occupational health and safety and property services. The offer ranges from laboratory analyses, auditing and certification of management systems to practical services for quality, safety, health and environmental protection. The focus is on customised solutions that can be seamlessly integrated into existing structures.

For over three decades, we have stood for reliable risk and compliance services in Europe. Our roots go back to 1985 and form the basis for sound expertise in specialist topics such as water hygiene, hazardous substances, fire protection and health and safety management. Our interdisciplinary teams support companies in fulfilling complex legal requirements and creating safe working and environmental conditions. Through continuous development, strategic expansion and clear quality standards, our solutions cover regulatory requirements and create lasting stability in sensitive areas.

Since 2004, we have been strengthening expertise in fire safety – with nationally recognised qualifications, practical apprenticeship programmes and targeted training – ensuring that emergency services, authorities and companies are always working in line with the latest regulations. Tailor-made CPD programmes support teams in deepening their knowledge, expanding their skills and increasing safety in the long term. With a broad industry base and long-standing relationships, Xact is a key provider of sustainable training in the UK.
Certification & Compliance
Our specialized services ensure that your products and services meet the highest standards. We provide a comprehensive suite of offerings, including auditing, certification, and consulting, to safeguard compliance in areas such as sustainability, quality, and ESG.
ManagementSystems
Certification, auditing and verification services for management and sustainability systems: from AZAV and ISO standards to environmental, energy, information security and CO₂ topics – competent, accredited and future-orientated.
Learn more
As a nationally accredited certification body, we specialize in AZAV approvals for training providers and measures. Our team consists exclusively of former specialists and managers from the education sector and has in-depth knowledge of requirements, processes and market changes. We expertly guide small and medium-sized providers through the entire certification process and ensure transparency and efficiency. With our focus on digital processes, we modernize certification and create a smooth, up-to-date implementation.

We strengthen companies in terms of quality, sustainability and compliance. Our services range from the certification of management systems – including quality, environment, occupational health and safety, energy and information security – to specialized sustainability certificates such as SURE and RED-Zert. We also prepare environmental reports, carry out EMAS validations and are approved for CO₂ audits at airports. And since 2025, we have also been offering training courses to help companies set up modern management systems.

If you want to set up, develop and successfully certify management systems in accordance with standards, you need us: As a DAkkS-accredited certification body, we audit quality, environmental, energy, information security and labour management systems as well as industry-specific standards such as GMP+ or waste management companies. Our audit teams work efficiently, transparently and practically – with clear processes and comprehensible results that contribute to continuous improvement.
Sustainability
Consulting, analytics and digital solutions for sustainable corporate governance: carbon accounting, ESG and CSR strategies, climate management, reporting and robust analyses to reduce emissions and meet international standards.
Learn more
Since 1999, we have been developing scientifically sound sustainability solutions that combine environmental responsibility with economic feasibility. Our portfolio includes CO₂ accounting for products and organizations, life cycle assessments, and the calculation of carbon footprints. In addition, DFGE supports companies in international ratings and reporting frameworks such as the UN Global Compact, GRI, EcoVadis, and CDP. With precise calculations, clear data, and powerful software solutions, we help you measure, reduce, and systematically integrate sustainability into existing processes.

We support your company on the path to greater climate protection – in a structured, transparent and practical way. Our services range from precise CO₂ balancing and the development of effective reduction measures to certified offsetting projects. Our software solutions make it easier to calculate, report and communicate on all aspects of climate issues. We are also involved in PROJECT TOGO in West Africa, where reforestation, environmental protection and social development go hand in hand. This is how we have been combining economic responsibility with real, measurable climate benefits for over 15 years.

We have been helping companies to take on sustainable responsibility and develop future-proof business models since 2010. From Italy to Austria and Germany, we provide support along the entire ESG transformation – from strategy and CO₂ reduction to circular economy and supply chains to cultural and leadership development. Our systemic, people-centred approach combines expertise with practical implementation. With the digital Terra Academy, we strengthen sustainability expertise and accelerate transformation. As part of the CERTANIA Group, we make organisations more resilient and impact-oriented.